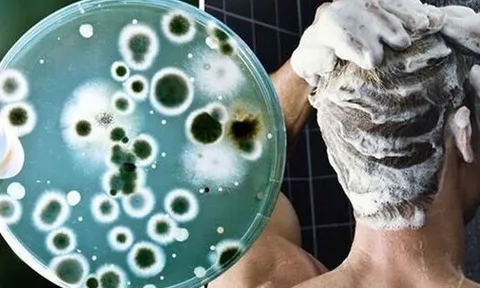
Bác sĩ cảnh báo: Không vệ sinh thứ này trong phòng tắm đúng cách có thể gây tổn thương da, phổi

Khánh Hòa: Nối thành công cổ chân bị đứt gần lìa cho bệnh nhân 25 tuổi
Một nam bệnh nhân bị máy cắt cỏ cắt vào cổ chân trái gây ra vết thương đứt gần lìa cổ chân, được các bác sĩ Bệnh viện Đa khoa tỉnh Khánh Hòa nối lại thành công.
Đột phá từ 100 nhà khoa học: Giải mã bí ẩn lớn nhất của quý ông
Một nghiên cứu quốc tế vừa công bố trên tạp chí Nature lần đầu tiên lấp đầy "khoảng trống" hiểu biết về nhiễm sắc thể Y, hứa hẹn nhiều đột phá mới liên quan sức khỏe ở quý ông.
Bác sĩ cảnh báo: Không vệ sinh thứ này trong phòng tắm đúng cách có thể gây tổn thương da, phổi
Bác sĩ cảnh báo, việc giữ phòng tắm sạch sẽ có ý nghĩa vô cùng quan trọng với sức khỏe của bạn.
Vụ đầu độc khiến 4 mẹ con tử vong: Khí CO nguy hiểm thế nào?
Cacbon monoxit (khí CO) được gọi là kẻ giết người thầm lặng, loại khí này thường gây ra những cái chết “êm ái” không báo trước.
Bé trai 5 tuổi bị thủng màng nhĩ do ngoáy tai
Một bé trai 5 tuổi ở TP Vinh, Nghệ An đang ngoáy tai bằng đồ lấy ráy tai của người lớn thì em gái vô tình va vào làm que ngoáy đâm gây chảy máu tai, thủng màng nhĩ, sức nghe giảm 50%.
Từ vụ bé trai 8 tuổi bị trói vào cột điện: Bạo hành mang đến tổn thương tâm lý nghiêm trọng thế nào với trẻ em?
Bạo hành có thể dẫn đến những tổn thương tâm lý nghiêm trọng đối với trẻ em, mang lại những hậu quả lâu dài trong tương lai.
Hơn 100 thuốc, vị thuốc cổ truyền được gia hạn, cấp mới giấy lưu hành
Việc gia hạn, cấp mới giấy đăng ký lưu hành các vị thuốc y học cổ truyền nhằm phục vụ nhu cầu khám chữa bệnh, phòng chống dịch bệnh của nhân dân.
Tp.HCM: Công khai chất lượng phòng khám thẩm mỹ để người dân lựa chọn
Đại diện Sở Y tế Tp.HCM cho biết, Sở này chính thức công khai điểm chất lượng các phòng khám thẩm mỹ, theo thang điểm chất lượng từ cao xuống thấp.
Tuổi thọ người Việt giảm nhẹ do COVID-19
Người dân Việt Nam có tuổi thọ tương đối cao nếu so với các quốc gia có cùng mức sống, nhưng lại có số năm sống với bệnh tật nhiều
Bệnh viện K bác thông tin viện phí do một số cán bộ y tế tự quyết
Ngày 23-8, trước một số clip video đang lan truyền trên mạng xã hội về việc người bệnh khi đi khám tại Bệnh viện K cơ sở Tân Triều phải trả viện phí theo sự quyết định của một số cán bộ y tế, đại diện Bệnh viện K đã thông tin cho báo chí về việc này.
“Không mua thảo dược như bà nội trợ mua rau”
Với thói quen dùng “thuốc truyền miệng”, đặc biệt, nhiều người cho rằng thuốc nam, thuốc đông y là lành tính nên thường sử dụng tràn lan. Không khó để bắt gặp những hàng bán thảo dược rải bạt trên vỉa hè trong các khu chợ cóc, chợ dân sinh, có thể dễ dàng mua bán.
Đề xuất để bệnh viện công chủ động xây dựng giá viện phí theo yêu cầu
Ngày 25-8, tại hội thảo nâng cao năng lực quản lý bệnh viện và vai trò của giám đốc bệnh viện trong tình hình mới do Sở Y tế Hà Nội tổ chức, đại diện nhiều bệnh viện đã nêu rõ khó khăn, vướng mắc trong việc thực hiện quyền tự chủ và đấu thầu, mua sắm trang thiết bị y tế, thuốc men.
Xem phim cùng con, người mẹ có hành động khiến bác sĩ tâm lý nói: Sẽ không bao giờ xảy ra tại nước ngoài
Câu chuyện giáo dục giới tính tại Việt Nam vẫn là một "lỗ hổng" lớn do phần lớn cha mẹ chưa thể làm bạn với con, hướng dẫn con đi đúng đường.
Suýt mất chân từ một vết côn trùng cắn
Bệnh nhân bị sốc độc tố từ một vết côn trùng cắn dẫn đến viêm cân mạc hoại tử cẳng chân trái và suy thận được các bác sĩ chẩn đoán, điều trị kịp thời giữ được tính mạng, không phải cắt cụt chi.